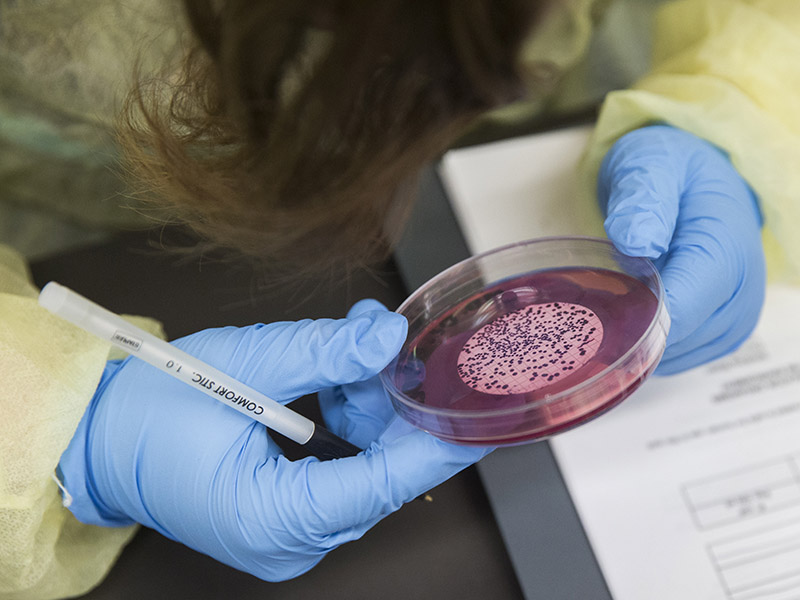

You are now in the main content area
Research

The School of Occupational and Public Health is a leading centre for injury and disease prevention research.
Our research activities develop practical solutions to important health and safety challenges in this city, across the country and around the world.